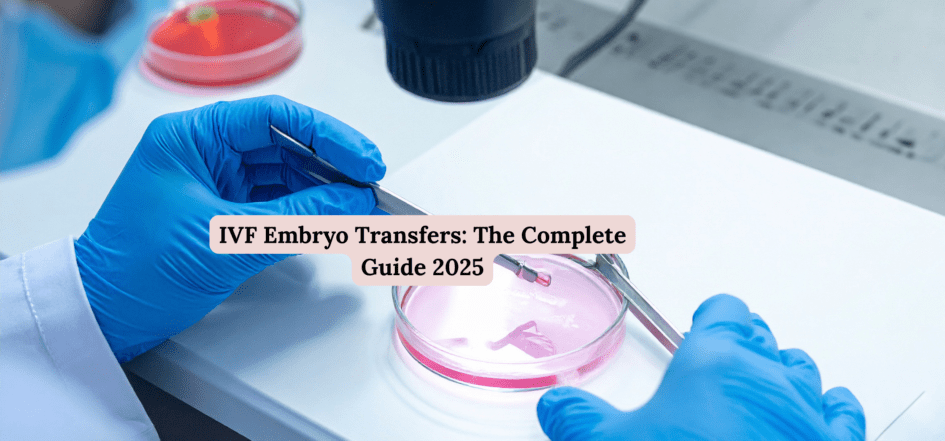

Introduction
Have you ever wondered what really happens during an IVF embryo transfer—the final and most emotional step of the IVF journey? For many couples, it’s that defining moment filled with hope, nerves, and anticipation. As we move into 2025, advancements in technology and fertility science have made this process more precise and successful than ever before.
In this comprehensive guide, we’ll walk you through every stage of IVF embryo transfer—from preparation to post-transfer care—using simple, everyday language. Whether you’re planning IVF soon or just exploring your options, this guide will help you understand what to expect and how the best IVF specialist in New Delhi can make all the difference.
- Understanding IVF Embryo Transfer
An IVF embryo transfer is the final stage of the in-vitro fertilization process where a developed embryo is placed into the woman’s uterus. Think of it as planting a seed into fertile soil– where it can grow, develop, and eventually become a healthy baby.
The embryo, created by fertilizing an egg with sperm in a lab, is carefully inserted into the womb using a thin catheter. It’s a quick, usually painless procedure that holds the power to change lives.
- Why Embryo Transfer Is Crucial in IVF
The embryo transfer marks the transition from laboratory science to natural biology. It’s where technology meets the miracle of life. A successful transfer means the embryo has attached itself (implanted) into the uterine lining, leading to pregnancy.
Even if everything else– egg quality, sperm count, and fertilization– goes perfectly, implantation is the true test of success. That’s why choosing an experienced IVF specialist and following the right care plan is essential.
- Fresh vs. Frozen Embryo Transfer
There are two types of embryo transfers:
Fresh Embryo Transfer– The embryo is transferred a few days after fertilization.
Frozen Embryo Transfer (FET)– The embryo is frozen and transferred later in a future cycle.
In 2025, frozen transfers have gained popularity because they allow the woman’s body time to recover from hormone stimulation. They also give specialists better control over timing, improving implantation rates.
- Step-by-Step Process of IVF Embryo Transfer
Here’s a simple breakdown:
Embryo Selection– The healthiest embryos are chosen based on growth and quality.
Endometrial Preparation– Hormonal medications help thicken the uterine lining.
Embryo Thawing (for FET)– If frozen, the embryo is gently thawed.
Transfer Procedure– A thin catheter is used to place the embryo inside the uterus.
Rest and Recovery– The patient rests for a short while before going home.
The procedure itself takes about 10– 15 minutes and doesn’t require anesthesia in most cases.
- Preparing Your Body for Embryo Transfer
Your body is like a garden– you want the soil (uterus) ready before planting the seed (embryo). Preparation may include:
Maintaining a balanced diet rich in iron, folate, and protein.
Avoiding alcohol, caffeine, and smoking.
Managing stress through yoga or meditation.
Following all prescribed hormonal medications precisely.
Staying healthy physically and mentally gives your embryo the best chance to thrive.
- What Happens on the Day of Transfer
On transfer day, you’ll likely visit your clinic with excitement and a bit of nervousness. Here’s what usually happens:
You’ll be asked to come with a full bladder, which helps guide the embryo into the right spot via ultrasound.
The specialist will carefully insert the catheter and release the embryo into the uterus.
After the transfer, you’ll rest for about 20– 30 minutes before going home.
It’s a simple, outpatient procedure– but emotionally, it’s one of the biggest moments of your IVF journey.
- Post-Transfer Care and Lifestyle Tips
After embryo transfer, your body needs calm, not chaos. Follow these tips:
Avoid heavy workouts or lifting.
Get plenty of rest, but don’t stay in bed all day.
Eat light, nutritious meals.
Stay hydrated.
Continue taking prescribed medications like progesterone.
Stay positive– stress hormones can impact implantation.
Remember, implantation happens naturally within 6– 10 days, so patience is key.
- Common Symptoms After Embryo Transfer
Every woman experiences this phase differently. Some common symptoms may include:
Mild cramping or bloating
Breast tenderness
Light spotting
Fatigue
Mood changes
These can be early pregnancy signs– or simply the effect of medications– so avoid overanalyzing every symptom.
- How to Improve Implantation Success
Here are proven ways to improve implantation:
Follow your medication plan strictly.
Eat fertility-boosting foods like avocados, leafy greens, and whole grains.
Avoid stress through meditation or journaling.
Trust your doctor– personalized care makes a difference.
The best IVF clinics in New Delhi also use embryo glue, time-lapse imaging, and endometrial receptivity tests to increase success rates.
- Role of Embryo Grading and Quality
Embryo grading is like quality-checking before planting. It helps doctors identify which embryos have the best chance of implanting.
High-grade embryos (with balanced cell division and minimal fragmentation) generally lead to better pregnancy outcomes. However, even lower-grade embryos can sometimes surprise everyone– it’s all about how the body responds.
- Latest Technological Advancements in 2025
In 2025, IVF has become smarter, safer, and more personalized. Here’s what’s new:
AI-assisted embryo selection for higher accuracy
3D imaging for uterine assessment
Non-invasive genetic testing to ensure healthy embryos
Precision hormone monitoring to optimize timing
These innovations have increased IVF success rates significantly, especially under the guidance of the best IVF specialist in New Delhi, who combines expertise with advanced technology.
- Emotional Health During IVF
Let’s be honest– IVF isn’t just physical; it’s an emotional rollercoaster. Between hope, anxiety, and waiting, it can feel overwhelming.
Take care of your emotional health by:
Talking to your partner openly.
Joining IVF support groups.
Practicing mindfulness and gratitude.
Avoiding excessive online symptom searches!
Think of emotional stability as the invisible fertilizer that helps your body prepare for pregnancy.
- Choosing the Best IVF Specialist in New Delhi
Finding the best IVF specialist in New Delhi can make all the difference. Here’s what to look for:
Experience and success rates– Ask about live birth rates, not just pregnancy rates.
Personalized care– Every patient’s body and journey are unique.
Advanced technology– Clinics that use AI and genetic screening have better outcomes.
Patient reviews and transparency– Trust builds confidence.
Top fertility experts in New Delhi focus on compassionate, evidence-based care, helping couples achieve parenthood dreams safely.
- Myths vs. Facts About Embryo Transfers
MythFact
You must stay in bed after transferLight activity is actually beneficial
Embryo transfer guarantees pregnancyIt increases chances, but doesn’t ensure it
Multiple embryos mean higher successIt can raise risk of twins, not always success
You can’t sneeze or laugh after transferNormal body movements don’t affect implantation
Knowledge is power– understanding the truth helps you stay calm and confident throughout your IVF journey.
- Conclusion and Key Takeaways
The IVF embryo transfer is not just a medical procedure– it’s a beautiful blend of science, hope, and emotion. In 2025, advancements in fertility technology have made the process safer and more successful, but emotional readiness and proper guidance remain just as important.
Choosing the best IVF specialist in New Delhi ensures you get the right expertise, modern care, and emotional support every step of the way. Remember, patience and positivity are your biggest allies– because sometimes, miracles take a little science and a lot of heart.
FAQs
- How long should I rest after an embryo transfer?
A short rest of 20– 30 minutes at the clinic is sufficient. You can resume normal light activities afterward but avoid strenuous exercise.
- When can I take a pregnancy test after IVF embryo transfer?
You should wait about 10– 14 days after the transfer before taking a blood test for accurate results.
- Can stress affect my chances of implantation?
Yes, excessive stress can disrupt hormonal balance. Try meditation, gentle yoga, or deep breathing to stay relaxed.
- What are the success rates for IVF embryo transfers in 2025?
With modern techniques, success rates in 2025 range from 55– 70%, depending on age, embryo quality, and clinic expertise.
- Why should I choose the best IVF specialist in New Delhi for my treatment?
Top specialists in New Delhi offer advanced technology, individualized care, and high success rates– helping you turn your dream of parenthood into reality.